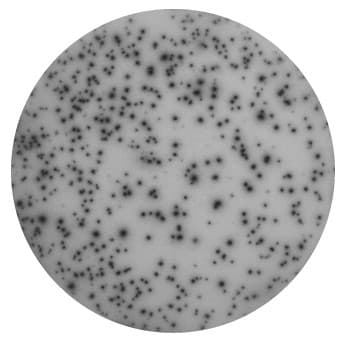
Click to enlarge

BKV PepPool available
Published: March 17, 2023
Updated: October 18, 2023
2 minute read
Authored by: Lara Mentlein
What's new?
We added a new peptide pool to our webshop – PepPool: BKV (CD4 and CD8), human. We’ve confirmed that this peptide pool elicits a response in PBMCs from some blood donors in human IFN-γ ELISpot. This PepPool includes peptides of the following viral proteins: Large T, Small T, and VP1. Of the 65 peptides included, 50 are MHC class I-restricted, and 15 are MHC class II-restricted. Therefore, this peptide mix allows you to identify antigen-specific CD4 as well as CD8 T cell responses.
Why does research around the BK virus matter?
The BK virus (BKV) belongs to the polyomavirus family. Polyomaviruses are double-stranded DNA viruses without an envelope, where the circular genome of around 5000 base pairs is packed in a viral capsid. BK is an abbreviation of the first patient's name that the virus has been isolated from.
BKV infections are widespread; more than 80% of individuals are infected by early childhood. The infection is typically asymptomatic, and the virus stays latent, often in the kidneys. However, in immunocompromised and immunosuppressed individuals, BKV infections may turn symptomatic. For example, the infection can lead to graft loss or organ rejection in transplanted patients (mainly kidney transplanted).
If you plan your first BKV experiment, remember that BKV has 75% sequence similarity to the JC (John Cunningham) virus. The JC virus is typically a latent virus that can be reactivated in immunocompromised individuals and cause progressive multifocal leukoencephalopathy.